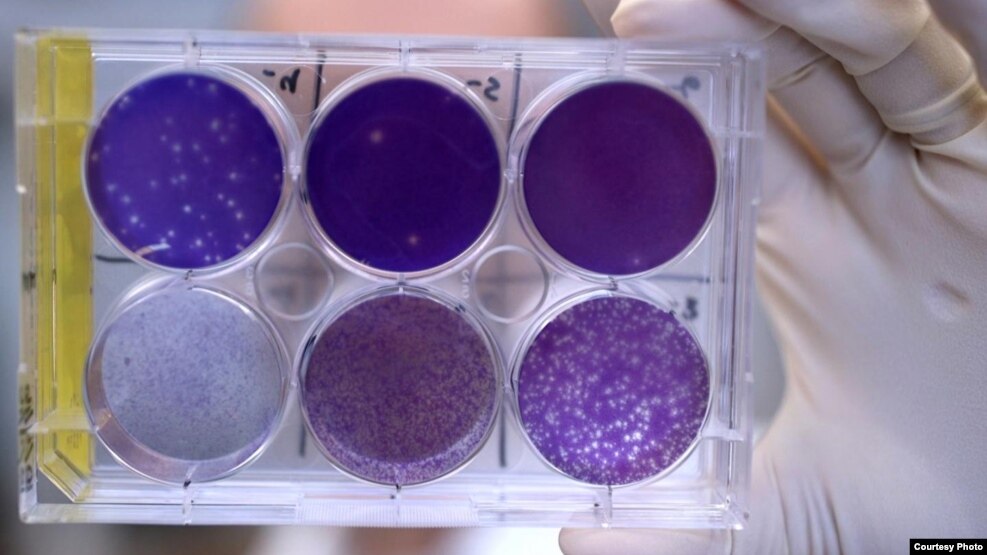

รู้จัก 'เชื้อไวรัสสามชนิด' ที่สร้างความกังวลมากที่สุดต่อวงการสาธารณสุขโลกในปี 2016
เชื้อไวรัสซิกา โปลิโอและเอชไอวี เป็นไวรัสสามชนิดที่ก่อให้เกิดปัญหาคุกคามด้านสาธารณสุขมากที่สุดในปี 2016 ที่ผ่านมา
เชื้อไวรัสซิกา
ในช่วงสองปีที่ผ่านมา จำนวนเด็กทารกที่มีคลอดออกมาพร้อมกับความผิดปกติของขนาดศีรษะที่เล็กมากได้เพิ่มขึ้นในอเมริกาใต้ แสดงให้เห็นว่าเชื้อไวรัสซิการ้ายเเรงกว่าที่คิด
เชื้อไวรัสซิกากำเนิดขึ้นในอูกันดาเมื่อ 60 กว่าปีที่แล้ว โดยระบาดผ่านยุงที่เป็นพาหะนำเชื้อและผ่านทางเพศสัมพันธ์ เชื้อไวรัสชนิดนี้ได้เเพร่ระบาดในประเทศบราซิล และระบาดขึ้นไปทางเหนือ พบผู้ติดเชื้อหลายคนในรัฐฟลอริด้า และเจ้าหน้าที่สาธารณสุขในรัฐเท็กซัสกังวลว่าเชื้อไวรัสซิกาอาจกำลังระบาดในรัฐ
เชื้อไวรัสซิกากำเนิดขึ้นในอูกันดาเมื่อ 60 กว่าปีที่แล้ว โดยระบาดผ่านยุงที่เป็นพาหะนำเชื้อและผ่านทางเพศสัมพันธ์ เชื้อไวรัสชนิดนี้ได้เเพร่ระบาดในประเทศบราซิล และระบาดขึ้นไปทางเหนือ พบผู้ติดเชื้อหลายคนในรัฐฟลอริด้า และเจ้าหน้าที่สาธารณสุขในรัฐเท็กซัสกังวลว่าเชื้อไวรัสซิกาอาจกำลังระบาดในรัฐ
Dr. Anthony Costello แห่งองค์การอนามัยโลก กล่าวว่า เเม้จะมีเด็กที่สมองพิการจากเชื้อไวรัสซิกาเพียงคนเดียว ก็จะส่งผลกระทบอย่างมากต่อทรัพยากรในชุมชน และกระทบต่อความสามารถของครอบครัวในการดูแล
เขากล่าวว่าโรคนี้เป็นปัญหาสาธารณสุขที่สร้างความกังวลอย่างมากแก่โลก ในช่วงสองปีที่ผ่านมาเชื้อไวรัสซิการะบาดเเล้วใน 69 ประเทศทั่วโลก เป็นเชื้อไวรัสที่สร้างความพิการแก่สมอง และอาจเป็นเหตุให้เกิดความพิการไปตลอดชีวิต ซึ่งส่งผลกระทบที่ใหญ่หลวงแก่ครอบครัว
ขณะนี้เเพทย์ทำได้เพียงเเค่เเนะนำผู้หญิงไม่ให้เดินทางไปในพื้นที่ระบาดของโรค เพื่อหลีกเลี่ยงไม่ให้ถูกยุงกัด หรือเลื่อนแผนการตั้งครรภ์ออกไปก่อน ตอนนี้ยังไม่มีวัคซีนป้องกันเชื้อไวรัสซิกา แต่คาดว่าอาจจะมีวัคซีนป้องกันโรคนี้ออกมาให้ใช้ในราวปีค.ศ. 2018

One-year-old Jose Wesley Campos, who was born with microcephaly, cries during a physical therapy session at the AACD rehabilitation center in Recife, Brazil, Sept. 28, 2016.
เชื้อไวรัสโปลิโอ
ในไนจีเรีย พบว่าเชื้อไวรัสโปลิโอกลับไประบาดอีกในทางเหนือของประเทศ ซึ่ีงเป็นพื้นที่เสียหายจากความขัดเเย้งทางอาวุธ ปัญหาความขัดเเย้งทางอาวุธนี้ทำให้เด็กๆ ในพื้นที่ไม่ได้รับวัคซีนป้องกันโรคนี้กันทุกคน
เมื่อปีที่ผ่านมาพบว่ามีเด็กเล็กอย่างน้อย 3 คนที่ได้รับการวินิจฉัยว่าติดเชื้อไวรัสโปลิโอ ในขณะที่ไนจีเรียเกือบจะปลอดจากเชื้อไวรัสชนิดนี้เเล้ว
นอกจากนี้ เชื้อไวรัสโปลิโอยังระบาดในพื้นที่เสียหายจากความขัดเเย้งทางอาวุธอีกแห่งหนึ่ง คือบริเวณชายแดนระหว่างปากีสถานกับแอฟกานิสถาน
การติดเชื้อโปลิโอรายใหม่ได้ลดลงถึง 99 เปอร์เซ็นต์ตั้งเเต่ปี ค.ศ. 1988 เป็นต้นมา จาก 350,000 ราย จนเหลือเเค่สามสิบกว่ารายในปีที่ผ่านมา

Vaccination workers give a boy polio vaccine drops on a street in Quetta, Pakistan, Jan. 2, 2017.
เชื้อไวรัสเอชไอวีและโรคเอดส์
ในตอนต้นเดือนธันวาคมที่ผ่านมา Dr. Anthony Fauci แห่งสถาบันสาธารณสุขแห่งชาติสหรัฐฯ ได้ประกาศเริ่มต้นการทดสอบวัคซีนป้องกันเชื้อไวรัสเอดส์ในคนครั้งสำคัญ โดยวัคซีนนี้กำลังอยู่ระหว่างการทดลองและพัฒนา
Dr. Fauci กล่าวว่า การคิดค้นพัฒนาวัคซีนเอชไอวีเป็นงานที่ท้าทาย griktไม่มีทางรู้ได้เลยว่าจะพัฒนาเป็นวัคซีนป้องกันเอชไอวีได้สำเร็จหรือไม่ อย่างไรก็ดี Dr. Fauci กล่าวชื่นชมความก้าวหน้าอย่างมากในการบำบัดโรคเอดส์ที่ผ่านมา
Dr. Fauci กล่าวว่าปัจจุบันนี้ การผสมผสานยาบำบัดเอชไอวีหลายอย่างร่วมกันช่วยให้ผู้ติดเชื้อมีชีวิตอยู่ได้นานขึ้น โดยเฉพาะผู้ติดเชื้อที่อายุราวยี่สิบปีและได้รับการบำบัด ซึ่งเป็นไปได้ว่าผู้ติดเชื้อเหล่านี้จะมีอายุได้อีกถึง 50 ปี
Dr. Fauci ชี้ว่านี่เป็นผลจากความคืบหน้าอย่างมากของการวิจัยด้านโรคเอดส์ที่มีประโยชน์ทางการแพทย์ และหากสามารถพัฒนาวัคซีนป้องกันเอเชไอวีที่มีประสิทธิภาพได้สำเร็จ วัคซีนนี้อาจจะช่วยกำจัดเชื้อไวรัสเอชไอวีให้หมดไปจากโลก
เอชไอวีเป็นเชื้อไวรัสที่ทำให้คนติดเชื้อไปเเล้วทั่วโลกมากกว่า 70 ล้านคน และทำให้คนเสียชีวิตไปแล้ว 35 ล้านคนในช่วง 50 กว่าปีที่ผ่านมา
ที่มา: http://www.voathai.com/
0 ความคิดเห็น:
แสดงความคิดเห็น